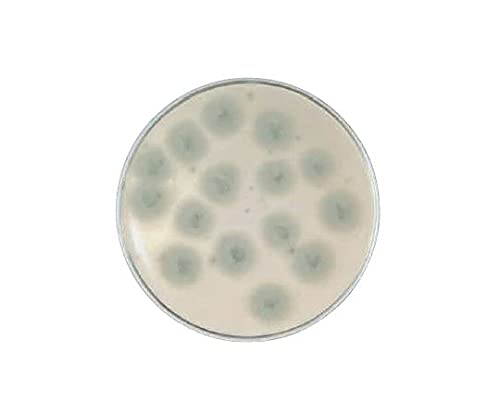
sunさま　専用ページ Sさん専用 Sさま 専用 ズーム直流電源 ZX-Sシリーズ | 高砂製作所

マイストア
変更
お店で受け取る
(送料無料)
配送する
納期目安:
2026.01.13 20:44頃のお届け予定です。
決済方法が、クレジット、代金引換の場合に限ります。その他の決済方法の場合はこちらをご確認ください。
※土・日・祝日の注文の場合や在庫状況によって、商品のお届けにお時間をいただく場合がございます。
sunさま 専用ページ Sさん専用 Sさま 専用 ズーム直流電源 ZX-Sシリーズ | 高砂製作所の詳細情報
Sさん専用 Sさま 専用 ズーム直流電源 ZX-Sシリーズ | 高砂製作所。SB2026_KH-scaled.jpg。LINK LINK EXPRESS 2025』選抜ナンバーオーディション開催! - 広島。ZN6 前期/後期 86/ハチロク サンシェード 汎用 UPF50/UVカット。。sunページ専用ページですので他の方のご購入はお控え下さいm(_ _)mワンダーフロッグ ワンダフレンドのお洋服カエルの王様 ・ 王冠(ピンク・ブルー・白・黒) ・ トップス×4 ・ パンツ×44着1着 3000円×4= 12000 ありがとうございますお値引き -200円合計 11800円 となりますm(_ _)mこの度もオーダー頂きありがとうございますm(_ _)mとても、感謝しておりますm(_ _)m♡
ベストセラーランキングです
近くの売り場の商品
カスタマーレビュー
オススメ度 4.9点
現在、2879件のレビューが投稿されています。